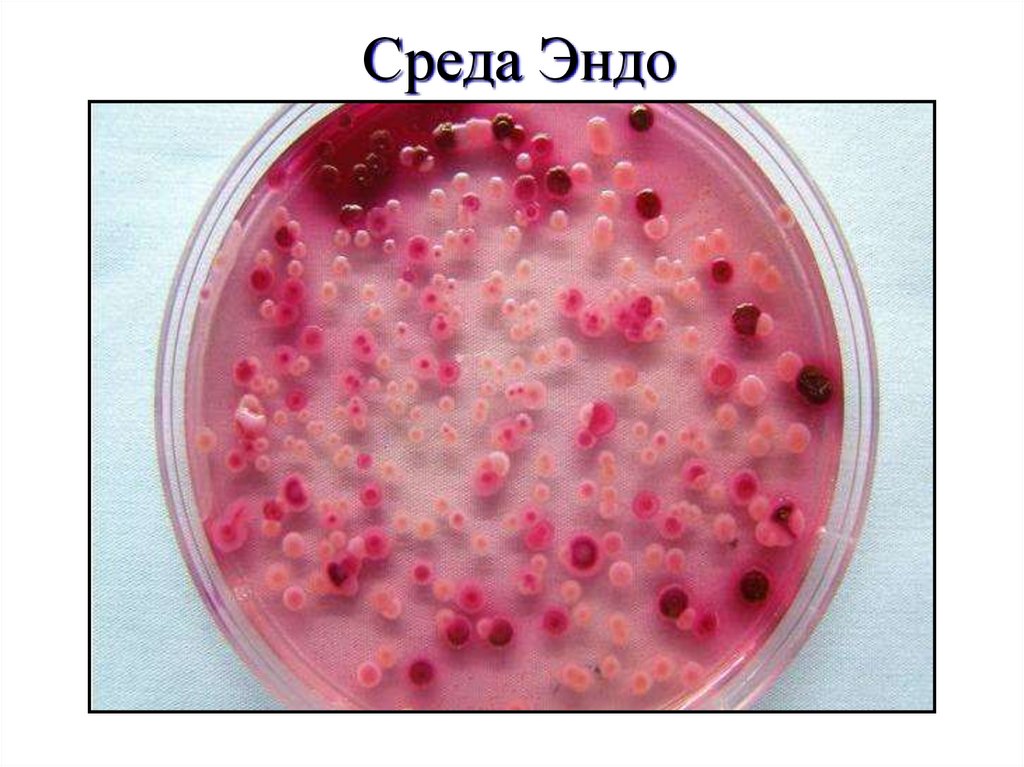
Среда Эндо
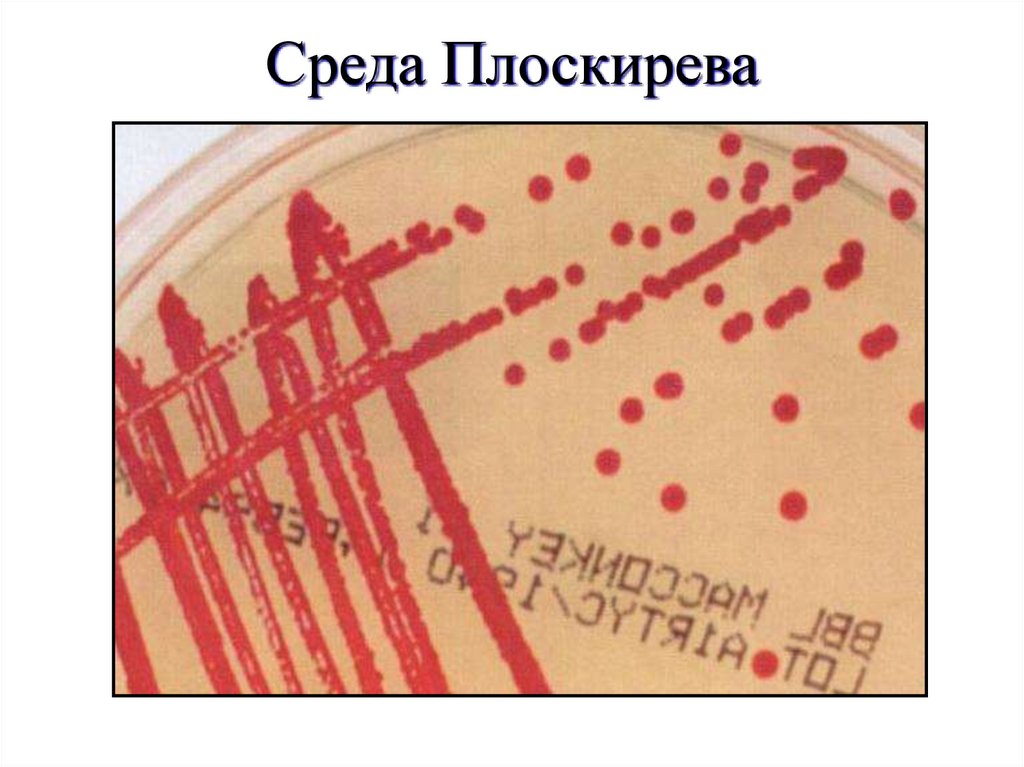
Среда Плоскирева

Похожие презентации:
Шигеллы и холерный вибрион (возбудители дизентерии и холеры)
1.
Шигеллы - Род Shigella (ВОЗБУДИТЕЛИ ДИЗЕНТЕРИИ)Название болезни введено Гиппократом в V в. до н.э.
Род Shigella получил название по имени Киёси Шига,
изучившего в 1898г. во время эпидемии дизентерии в
Японии возбудителя заболевания, современное
наименование которого - Shigella dysenteriae (подгр.А)
В Германии в 1900г такие бактерии обнаружил Kruse
В том же году S. Flexner изолировал дизентерийные
бактерии с отличными от других бактерий свойствами
они были названы его именем (подгр.В)
В 1915г. K.Sonne выделил и описал подобные
бактерии другого вида (подгр.Д)
В работах I.Boyd (1931-1940) описаны выделенные в
Индии 6 разнов. новых возбудителей дизентерии,
объединенных в подгр.С - Shigella boydii
2. Таксономическая характеристика
Семейство: EnterobacteriaceaeРод: Шигелла, включает 4 группы и
соответственно вида, различающиеся
по биохим-м свойствам и АГ составу
Группа дизентерийных микробов,
согласно Международной
классификации (1982г.), насчитывает
44 номенклатурных единицы
(серовары, подсеровары шигелл)
3.
• А - shigella dysenteriae(12 сероваров)
• В - shigella flexneri - 6 сероваров
с подсероварами
• С - shigella boydii (18 сероваров)
• D - shigella sonnei серологически
однородны (1 серовар)
4. Морфология
• Размер 2-3 (4) х 0,5-0,7 мкм;• Гр(-) палочки с закругленными полюсами
• Жгутиков не имеют, Н-АГ не образуют
• Капсула (±)
• Некоторые виды синтезируют К-АГ
• Споры (-)
• Имеются половые F-пили (конъюгация)
• Большинство шигелл снабжены фимбриями
общего типа, которые выполняют функцию
адгезии к эпителию слизистой оболочки
толстой кишки
5.
Шигеллы6.
Физиология микроба• Факультативные анаэробы
• Шигеллы поражают толстый кишечник
(размножаются внутри эпителиальных клеток)
• Шигеллы индуцируют апоптоз ВПК
Биохимия микроба
• Метаболизм дыхательный и ферментативный
• Шигеллы биохимически практически инертны
Генетика
• Генетический контроль факторов вирулентности
шигелл осуществляется рядом хромосомных и
плазмидных генов
7.
Шигеллы8.
Антигенная характеристика• Н - АГ нет (Шигеллы неподвижны)
• О - АГ
- ЛПС
- Белковые антигены (24 антигена)
• К - АГ (у некоторых шигелл)
• Перекрестные АГ с другими
представителями семейства
энтеробактерий
9. Резистентность микроба
Шигеллы мало устойчивы к воздействию физических,химических и биологических факторов окруж. среды,
куда они попадают с испражнениями больных
дизентерией или бактерионосителей. Наиболее
чувствительны Shigella dysenteriae,наиболее
резистентные - S. sonnei
• 100°С - несколько секунд
• 60°С 10 -20 минут
• У/ф лучи 10 минут (прямой солнечный свет)
• 1% раствор фенола 30 минут
• В желудочном соке погибают через несколько мин
• В высушенных или замороженных фекалиях
жизнеспособны до нескольких месяцев
• В почве, воде, на предметах, посуде, пищевых
продуктах, сохраняются жизнеспособными до 2 нед.
10. Заболевание
• Дизентерия (шигеллез, бактериальнаядизентерия; от греч. dys - расстройство и
enteron - кишечник) представляет собой
острое антропонозное инфекционное
заболевание с
преимущественным
поражением
толстой кишки
11. Эпидемиология
Дизентерия распространена повсеместно. В некоторыхрегионах шигеллез остается эндемичным
Начиная с 80-х годов XX века во многих странах, в том
числе в США, отмечают рост заболеваемости
Эпидемиологию шигеллеза отличает изменение этиологии
До конца 1 Мировой войны основным возбудителем
была Shigella dysenteriae (группа А)
• Затем стали доминировать поражения, вызванные
Shigella flexneri (группа В)
• После II Мировой войны - Shigella sonnei ( группа D)
• В последние десятилетия на территории многих стран
Западной Европы, России и Африки преобладают
возбудители дизентерии двух видов - Шигеллы
Флекснера и Зонне
12.
ЭкологияШигеллы попадают в окружающую среду с
испражнениями больных
Источник
Антропонозное заболевание
• Единственный природный резервуар шигелл человек (больной или носитель)
• Период носительства: 1- 4 недели, редко дольше
• Основной источник пищевых инфекций в
развитых странах: устрицы, реже
инфицированное коровье молоко
• Переносчики шигелл: мухи, тараканы
13. Пути передачи инфекции
• Пероральный (= пищевой,алиментарно - водный,
энтеральный, фекальнооральный)
• Контактно - бытовой путь
передачи не может обеспечить
высокую интенсивность
эпидемического процесса
14. Восприимчивость
• Возрастной ИД (Чаще болеют дети от 3 месяцевдо 10 лет)
• Снижение фагоцитарной активности
• Снижение барьерной функции ЖКТ
• Дисбиозы (снижение антагонистического
действия микрофлоры кишечника)
• Нарушение пищеварения
• Снижение перистальтики
• Снижение секреции слизи
• Уменьшение пролиферативной активности
эпителиальных клеток кишечника
• Восприимчивость выше у лиц 2 группы крови(А)
15. Факторы патогенности
Экзотоксин (токсин Шига) обладает:• Энтеротоксическим действием (активация
аденилатциклазы)
• Цитотоксическое действие
- Гемолитическая активность in vitro
Инактивация 6О S субъединицы рибосом
• Нейротоксическое действие
Эндотоксин
• Вирулентный фенотип шигелл обусловлен наличием
полноценной структуры ЛПС, а также специфических
белков наружной мембраны
• Другие токсины с цитотоксическим действием
• Антилизоцимная активность
• Биологически активные вещества; пили
16. Особенности патогенеза
• Формирование инфекционного очага в СОнисходящего отдела толстого кишечника
(сигмовидная и прямая кишка), куда
проникает возбудитель дизентерии, носит
циклический характер:
адгезия, колонизация, внедрение шигелл в
цитоплазму энтероцитов, их внутриклеточное
размножение, разрушение и отторжение ЭК,
выход возбудителей в просвет кишечника;
вслед за этим начинается очередной цикл
17. КЛИНИКА
В результате повторяющихся цикловвоспалительный очаг разрастается,
образующиеся язвы, соединяясь,
увеличивают обнажённость кишечной
стенки, вследствие чего в
испражнениях появляются кровь,
слизисто-гнойные комочки, ПЯЛ
Клинику дизентерии определяют
экзотоксины, продуцируемые
шигеллами
18. Постинфекционный иммунитет
• Обусловлен антимикробными АТ- ми,антитоксинами, повышением
активности макрофагов и Тлимфоцитов. Значительную роль
играет местный иммунитет СО
кишечника опосредуемый Ig As
• Иммунитет носит типоспецифический
характер
19. Лабораторная диагностика
Основной метод - бактериологическийМатериал для исследования:испражнения
Посев на среды Эндо и Плоскирева
Идентифицируют по морфологическим,
культуральным, биохимическим
свойствам и при помощи
агглютинирующих диагностических
сывороток
20. Среда Эндо
21. Среда Плоскирева
22.
Среда Олькеницкого23. Серологическая диагностика и ПЦР
• РПГА• РСК
• ИФМ
• реакция коагглютинации
• РГА
• ПЦР – выявление ДНК
24. Лечение
• Основное внимание уделяетсявосстановлению нормального водносолевого обмена, рациональному
питанию, дезинтоксикации,
антибиотикотерапия (с учётом
чувствительности возбудителя к
лекарственным препаратам)
• Проблема специфической
профилактики остаётся нерешённой
25. Холерный вибрион Vibrio cholerae – возбудитель холеры
26.
Холера – антропонознаяособо опасная
токсикоинфекция,
характеризующаяся
профузной водянистой
диарей, крайней слабостью,
выраженной потерей
жидкости и электролитов
27.
28. История
Слово «холера» означает излияние желчиВозбудитель холеры V. cholerae впервые
был выделен и изучен Р. Кохом в 1882г.
В Египте Ф. Готшлих в 1906г. на
карантинной станции Eltor выделил из
кишечника паломников вибрион,
отличающийся от вибриона Коха
гемолитическими свойствами; как в
последствии оказалось, V. Eltor также
вызывает холеру
29. Эпидемия
Внезапное учащение инфекционныхзаболеваний, которое становится
массовым
Пандемия
это случай эпидемий, захватывающих
территории континентов и материков
30. Распространение инфекции
Холера периодически распространяется поЗемному шару. С 1817 г. по 1925 г.
отмечалось 6 пандемий. До 1960 г.
регистрировалось 6 эпидемий, которые
вызывал классический биовар V. Cholerae,
7-ая эпидемия охватила 39 стран мира, в
том числе европейские. Заболевания были
вызваны вибрионом Eltor. Наибольшее
число больных, более 170 тыс., было
зарегистрировано в 1971 г.
31. Пандемии холеры
1.2.
3.
4.
5.
6.
7.
1817-1826гг. Распространялось заболевание на страны ЮгоВосточной Азии в бассейне рек Ганга и Брахмапутра
1827-1837 гг. Сведения о возбудителе отсутствуют
1846-1862 гг. Забол-ть в Пакистане, Индии и Бангладеш
1864-1875 гг. Поражены Индонезийский архипелаг и страны
западного побережья Тихого океана
1883-1896 гг. Выявляются больные в Таиланде, на
Филиппинах, Корее
1900-1925 гг. Эпидемическая ситуация наблюдается в
странах Ближнего и Среднего Востока, Африке и достигает
Европы. Вспышки отмечаются в Испании, Португалии,
Италии, Австралии, Новой Зеландии. Единичные случаи
регистрируются в Японии, Швеции, Франции, Югославии,
Германии и России
С 1961 по настоящее время. Эпидемией охвачены 32 страны,
в том числе и Россия
32. Классификация
Семейство VibrionaceaeТиповой род Vibrio
Типовой вид Vibrio cholerae
Серогруппы
О1Н1
О139Н1
холероподобные О2-O83
биовары
V. сholerae
V. Eltor
(Коха) серовары
AB AC ABC AB AC ABC
AB - Огава
АС - Инаба
АВС - Гикошима
33. Общая характеристика бактерий
• Имеет форму изогнутой палочки, напоминающейзапятую, размерами 1,5-3,0х0,5мкм
• Грамотрицательные
• Спор не образуют
• Имеется капсула
• Один полярно расположенный жгутик
• По дыханию – аэроб
• Вирулентные штаммы высокоадгезивны,
авирулентные – слабо
• Имеют липидные компоненты
• Хитиназа
• Фосфотазы
34. Резистентность микроба
• Более устойчивы к действию факторовокружающей среды вибрионы биовара Eltor
• Вибрионы (биовар Коха) гибнут при действии ряда
факторов:
1. При высушивании, УФ, действии дезинфектантов
(3% раствор карболовой кислоты, HCI, спирт)
2. Температурное воздействие:
100°С несколько секунд, 60°С 30 минут, при
температуре ниже +15°С холерный вибрион не
жизнеспособен, 4°С: 1,5 мес., 0°С: 1 год
• Вибрионы длительно сохраняются в продуктах со
щелочной рН и высокой влажностью, а также на
одежде и постельном белье, загрязненных
испражнениями больных
35. Экология
• Обитатель кишечника• Эпидемические очаги: Индия, Африка, в
умеренном климате активность приобретает
когда вода прогревается выше +20С
Источник
• Контаминированная вода
• Больные, вибрионосители
• Африканские мухи
36. Факторы, повышающие восприимчивость
• Сниженная кислотность желудочногосока;
• Лица с первой группой крови О(I);
• Низкий социальный уровень жизни;
• Летальность без лечения – 30%.
37. Пути передачи
Водный путь (вибрионы длительно
циркулируют в открытых водоёмах,
канализационных и банно-прачечных водах);
Алиментарный (через рыбу, раков, креветок,
устриц, не подвергшихся должной термической
обработке);
Фекально-оральный;
Контактный (редко).
38. Факторы патогенности
• Экзотоксин, эндотоксин, ферменты,низкомолекулярные метаболиты, гемолизины,
лецитиназа,гиалуронидаза, муциназа,
токсинорегулируемые пили адгезии, ЛПС.
• Холероген белок с М. 84 кД, состоящий из одной
субъединицы А и пяти одинаковых субъединиц В.
• Часть А вызывает в организме активацию
аденилатциклазы, часть В связывается с
ганглиозидом Gm1 мембран эпителиоцитов.
• Свойство: Разворот «Водяного насоса» в
энтероцитах.
39.
ХолерогенСтойкая активация аденилатциклазы
Повышение концентрации цАМФ (в мукозальных клетках)
Интенсивное выделение из клеток
воды
Обильная диарея
ионов Na и CI
(нарушение поступления
ионов К внутрь клеток)
40. Патогенез
• Токсикоинфекция. Токсины и бактерии вкровь не поступают, воспалительная реакция
не развивается.
• Размножение в тонком кишечнике----Синтез
холерогена----Разворот водяного насоса---Обезвоживание организма---Повышение
вязкости крови---Нарушение водно-солевого
баланса----Сердечная недостаточность
41. Клиника
• Инкубационный период в среднем 2-3 дня (от нескольких часов до 5 дней)• Начало заболевания с диареи
• Лихорадка (у 70% больных) в течении 1-6 дней
• Рвота без тошноты, «фонтаном»
Стул профузный, водянистый, бесцветный с хлопьями, «рисовый отвар».
• Эксикоз без токсикоза.
• Последствия дегидратации: гиповолемия, гемоконцентрация.
• Усиливающаяся жажда, сухость кожи.
• «Лицо Гиппократа»
• Миалгии
• Цианоз кожи
• Гипотония
• Олигоурия
• Тахикардия
• Одышка
• Проявления гиповолемического шока у 30% больных
42. Степени тяжести заболевания (степени обезвоживания организма)
• I степень – потеря 1-3% жидкости от массы тела(стёртые и лёгкие формы заболевания). Длительность
болезни 1-2 дня.
• II степень – потеря 4-6% жидкости. Понос, рвота, жажда,
сухой язык с «меловым налётом». Кожа и СО бледнеют,
снижается тургор кожи. Отмечаются судороги, цианоз
губ и пальцев.
• III степень – потеря 7-9% жидкости. Наблюдаются резко
выраженные признаки эксикоза. Олиго- анурия,
гипокалиемия.
• IV степень – потеря жидкости 10% и более.
Гиповолемический шок, массивные беспрерывные
дефекации, рвота (до 20 л. жидкости в сутки).
43. Иммунитет
• Постинфекционный, непродолжительный.Повторное заболевание может наблюдаться
уже через 3-6 мес.
• Факторы защиты в слизистой кишечника:
комплемент «-», фагоцитоз «-» холерный
токсин ингибирует ПОЛ в макрофагах, Ат-зкЦ
«-», АГ-ЗКЦ «-», Ig A блокирует белки адгезии
44. Профилактика
1. Неспецифическая:• Использование энтеросорбентов
• Пероральное введение ганглиозида Gm1, связывающего
холерный токсин.
• Для экстренной профилактики используют тетрациклин
• Противоэпидемические мероприятия (локализация,
ликвидация очагов, борьба с загрязнением водоемов)
2. Специфическая:
• Активная иммунизация (вакцинация). В России массовая
вакцинация против холеры не проводится. Создано несколько
типов вакцин:
• Живая - для применения через рот
• Корпускулярная убитая (введение сначала парентерально,
затем перорально)
• Синтетическая
• Антитоксическая (холероген-анатоксин).
Диспансерное наблюдение – в течение одного года.
45. Лечение
1. Этиологическое• Антибиотикотерапия (стрептомицин,
тетрациклин, доксициклин)
2. Патогенетическое
• Устранение дегидратации (регидратация)
• Введение солевых растворов
• Внутривенное вливание изотонических
полионионных кристаллоидных растворов
3. Симптоматическое
• Высокобелковая диета кислого характера
46. Лабораторная диагностика
Материал: испражнения, рвотные массы,
промывные воды желудка.
Пищевые продукты.
Смывы с объектов окружающей среды,
секционный материал, одежда больного.
Вода.
Ускоренная диагностика:
Генетическая – ПЦР
Микроскопическая – ИФМ, окраска по Граму,
выявление подвижности «Висячая капля»
47. Холерный вибрион
48. Бактериологическая диагностика
Питательные среды:• Щелочная пептонная вода с рН= 8,5 – 9
(элективная среда).
• Щелочной МПА
• Тиосульфат-цитрат-сахарный агар с
добавлением солей желчи (TCBS-агар).
Биохимическая идентификация
49. Метод Ермоловой
• 3 пробирки:1. Со щелочным МПБ, рост в виде пленки на поверхности
2. + АТ к О1, хлопья при добавлении антисыворотк О1 (блокировка подвижности
антисывороткой)
3. + крахмал, Холерные вибрионы крахмал расщепляют
холерный вибрион (О1) холероподобный вибрионы (О2-…)
+О1- Крахмал+
АТ (светлая
пробирка)
Массовое скрининговое обследование.
+О1- Крахмал
АТ
синеет
50. Диагностика
Биохимические свойства• Г+, М-т+, М+, С+, Л-, гликоген+, крахмал+ с образованием
кислоты
• Ферментация маннозы, сахарозы, арабинозы(т.н. триада
Хейберга)
• Холерные вибрионы разлагают только маннозу и сахарозу
Серологическая диагностика
ИФМ
РА
РНТФ
РНГА торможение размножения вибрионов в присутствии
антител к ним (микробы +плазма больного)

Медицина
Медицина








